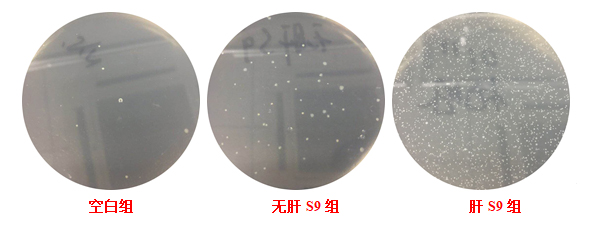
产品细节图片1

相关产品推荐更多 >
万千商家帮你免费找货
0 人在求购买到急需产品
- 详细信息
- 文献和实验
- 技术资料
- 提供商:
NGB
- 服务名称:
肝S9、肝微粒体和细胞浆定制服务
我们提供的肝S9、肝微粒体和细胞浆定制服务具有以下优势:
一、具有多年肝S9、肝微粒体和细胞浆分离提纯经验,技术路线成熟可靠;
二、定制服务周期短:正常情况下,一般仅需2-3周时间;
三、严格的质量检测:欣润生物提供的肝S9、肝微粒体和细胞浆均经过严格的质量检测和结果分析,并列出详细的实验步骤;
四、完善的售后服务:我们不仅提供给您优质的产品,同时还可以为您提供专业的技术支持,确保您正确使用定制化的肝S9、肝微粒体和细胞浆。
风险提示:丁香通仅作为第三方平台,为商家信息发布提供平台空间。用户咨询产品时请注意保护个人信息及财产安全,合理判断,谨慎选购商品,商家和用户对交易行为负责。对于医疗器械类产品,请先查证核实企业经营资质和医疗器械产品注册证情况。
 文献和实验
文献和实验%)等,这些代谢物与硫酸和葡萄糖醛酸结合(约30%)随尿排出,故测定尿中硫酸盐及尿酚的量可反映近期体内吸收的情况,一部分邻苯二酚也可氧化形成粘糠酸,然后分解为CO2和水排出体外。 留在体内的苯,主要分布在骨髓、脑及神经系统等含脂肪组织多的组织内,尤以骨髓中含量最多,约为血液中的20倍。苯的代谢主要在肝脏内进行。肝微粒体的混合功能氧化酶使苯羟基化,成苯基羟胺。 (二)毒性 苯属中等毒类。空气中苯浓度达2%时,人吸入后在5~10分钟内致死。成人摄入约15ml苯可引起
【资源】蛋白版2006年05月无人应助帖,请广大战友积极应助,加分从优!
=3&age=0 【求助】众位前辈,请问accute chemical公司的抗体质量如何 急 http://www.dxy.cn/bbs/post/view?bid=65&id=6160728&sty=1&tpg=3&age=0 【求助】如何研究已知蛋白的未知的非常规分泌途径?谢谢! http://www.dxy.cn/bbs/post/view?bid=65&id=6159219&sty=1&tpg=3&age=0 【求助】请问我要做细胞浆蛋白磷酸化的WESTERN BLOT 检测 ,请问
皮质激素有强大的抗炎作用,能对抗各种原因如物理、化学、生理、免疫等所引起的炎症。在炎症早期可减轻渗出、水肿、毛细血管扩张、白细胞浸润及吞噬反应,从而改善红、肿、热、痛等症状;在后期可抑制毛细血管和纤维母细胞的增生,延缓肉芽组织生成,防止糖连及瘢痕形成,减轻后遗症。但必须注意,炎症反应是机体的一种防御功能,炎症后期的反应更是组织修复的重要过程。因此,糖皮质激素在抑制炎症、减轻症状的同时,也降低机体的防御功能,可致感染扩散、阻碍创口愈合。 皮质激素抗炎作用的基本机制在于糖皮质激素(GCS)与靶细胞浆
 技术资料
技术资料暂无技术资料 索取技术资料










